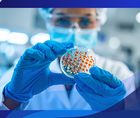
ReachMD Healthcare Image

Welcome to Global
Cardiology Academy
Enhance your cardiology practice with CME and
tools focused on heart health management.
Popular
Programs
Clinical Practice
CME
Medical News
- 04/20/2026
- 04/16/2026
- 04/13/2026
- 04/13/2026
- 04/01/2026
- 03/31/2026
- 03/31/2026
- 03/30/2026